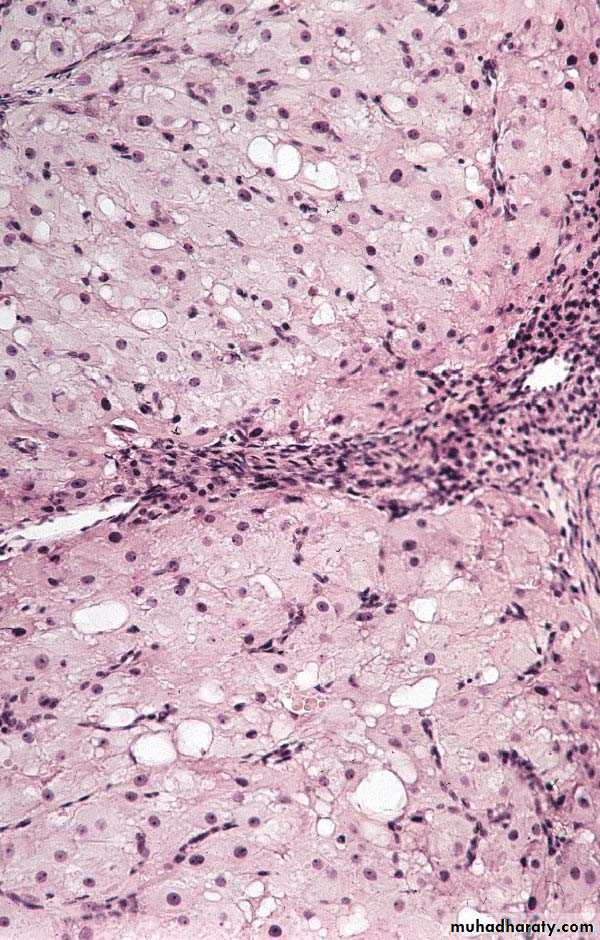

بسم الله الرحمن الرحيم
FEMALE REPRODUCTIVE SYSTEM
Prof.Dr. Huda Al-KhateebHead of Quality Assurence & Academic Performance
Head of Histology section/Dept. of Anatomy
College of Medicine/ Univ. of Baghdad
hmdk54@yahoo.com
objectives
1. Ovulation2.Corpus luteum
3.Uterine tube
Ovulation
It is the expulsion of primary oocyte from ovary. The ovum is caught by the dilated end of the uterine tube which is closely applied to the ovarian surface at that time.It normally occurs around the fourteenth day of a typical 28-day cycle.
In humans usually only one oocyte is liberated during each cycle, but sometimes two or more simultaneous oocytes may be expelled
Changes in mature follicle before ovulation
1.Just before ovulation the oocyte completes the first meiotic division, which it began and arrested in prophase during fetal life.2.The chromosomes are equally divided between the two daughter cells, but one of these retains almost all of the cytoplasm. That cell is now the secondary oocyte and the other becomes the first polar body, a very small nonviable cell containing a nucleus and a minimal amount of cytoplasm.
3.Immediately after expulsion of the first polar body, the nucleus of the oocyte begins the second meiotic division, which arrests this time in metaphase.
Changes in mature follicle before ovulation
In the hours before ovulation4.the large mature follicle bulging against the tunica albuginea develops a translucent ischemic area, the stigma.
5.Oocyte and its surrounding corona radiata detach from the follicular wall and float free in the follicular antrum
Changes in mature follicle before ovulation
6.Increase fluid production within the antrum of preovulatory follicle.7.The increasing pressure of the follicular fluid and weakening of the follicular wall lead to ballooning and then rupture of the ovarian surface at the stigma.
Changes in mature follicle before ovulation
8.The oocyte and corona radiata, along with follicular fluid and cells from the cumulus, are expelled through this openingJust after ovulation
The ovulated secondary oocyte (ovum) is drawn into the opening of the uterine tubeIn the uterine tube
Either it is fertilized within 24 hoursOr
If not fertilized within about 24 hours, the secondary oocyte begins to degenerate
Medical applicationClinical assessment ovulation
Corpus Luteum
After ovulation, the granulosa cells and theca interna of the ovulated follicle reorganize to form a larger temporary endocrine gland, the corpus luteum (yellowish body), in the ovarian cortex.Corpus Luteum
Ovulation causes the collapse and folding of the granulosa and thecal layers of the follicle's wall and blood from disrupted capillaries typically accumulates as a clot in the former antrum..Corpus Luteum
Granulosa cells increase greatly in size, without dividing, and eventually comprise about 80% of the parenchyma of the corpus luteum. They are called granulosa lutein cells and now have lost many features of protein-secreting cells to expand their role in aromatase conversion of androstene-dione into estradiol.Corpus Luteum
The theca interna cells will form theca lutein cells.These cells are less than half the size of the granulosa lutein cells, more peripheral and often stain more darkly, with cytoplasmic ultrastructural features of steroid-synthesizing cells. LH causes these cells to produce large amounts of progesterone as well as androstene-dione.
Fate of Corpus Luteum
If pregnancy does not occur, corpus luteum will remain secreting progesterone for 10–12 days, then its tissue regresses. A consequence of the decreased secretion of progesterone is menstruation.The corpus luteum that persists for part of only one menstrual cycle is called a corpus luteum of menstruation
Fate of Corpus Luteum
Fate of Corpus Luteum
If pregnancy occurs, the trophoblast cells of the implanting embryo produce human chorionic gonadotropin ( HCG ) that stimulate further growth of corpus luteum and more secretion of progesterone to maintain the uterine mucosa.Corpus luteum of pregnancy becomes very large and is maintained by HCG for 4–5 months.
Corpus Luteum of pregnancy
Corpus albicans
Both types of corpus luteum, when degenerate will end with the formation of corpus albicans (white body). It is a scar (dense connective) tissueCorpus albicans
Uterine Tubes
The uterine tubes, or oviducts are two muscular tubes with considerable mobility, each measuring about 12 cm in length.Each has a funnel-shaped end, the infundibulum, opening into the peritoneal cavity next to the ovary and with a fringe of fingerlike extensions called fimbriae.
Uterine Tubes
The sequence of regions along each tube is as follows:1. the infundibulum
2. the ampulla, the longest and expanded area where fertilization normally occurs
3. the isthmus, a more narrow region nearer the uterus
4. the uterine or intramural part, which passes through the wall of the uterus and opens into the interior of this organ.
Uterine Tubes
The wall is composed of1.Mucosa
2.Muscular layer
3.Serosa
Uterine Tubes
MUCOSA is highly foldedUterine Tubes
The mucosa has numerous branching, longitudinal folds that are most prominent in the ampulla, which in cross section resembles a labyrinth. These mucosal folds become smaller in the segments of the tube closer to the uterus and are not present in the intramural portion of the tubeUterine Tubes
Mucosa is composed of1.Simple columnar epithelium ulternating ciliated and secretory (Peg cells)
2. Lamina propria – loose connective tissue
Uterine Tubes
The epithelium contains two interspersed, functionally important cell types:ciliated cells; The cilia beat toward the uterus
secretory cells, or peg cells; responsble for secretion of viscous liquid film that covers the epithelial surface and contains glycoproteins and nutritive components produced by the secretory cells.
Uterine Tubes
At the time of ovulation,the uterine tube shows active movement. The infundibulum moves very close to the ovary and partially covers its surface. This favors the transport of the ovulated secondary oocyte into the tube. Promoted by sweeping muscular contractions of the fimbriae and ciliary activity of the epithelium.
Uterine Tubes
the oocyte enters the infundibulum and moves to the ampulla.The secretion covering the mucosa has nutrient and protective functions for the oocyte and the sperm, including factors that promote sperm activation (capacitation).
Uterine Tubes
The oocyte typically remains viable for a maximum of about 24 hours if it is not fertilizedUterine Tubes
Fertilization usually occurs in the ampulla.Fertilization triggers the oocyte to complete the second meiotic division, with formation of the ovum and release of a second polar body.
The corona radiata is generally still present when the sperm fertilizes the oocyte and its cells gradually detach over the next several hours
Uterine Tubes
The diploid cell formed during fertilization, the zygote (Gr. zygotos, yoked together), begins cell division and is transported to the uterus, which takes about 7 days.Uterine Tubes
Muscular layer is thick and composed of interwoven circular (or spiral) and longitudinal layers of smooth muscleSerosa very thin and covered by visceral peritoneum ( mesothelium).
Uterine Tubes
Contractions of the oviduct muscle layers, together with ciliary movement of the film covering the mucosa, transport the early embryo toward the uterus.MEDICAL APPLICATION
Uterine tubes are commonly called fallopian tubes, after the 16th century anatomist Fallopius, and in medical terminology are frequently denoted by the prefix "salping-"salpingitis" for inflammation of the tubal lining and "salpingectomy" for surgical removal of these structures.
MEDICAL APPLICATION
In a woman whose uterine tube is blocked by post-inflammation scar tissue, the embryo cannot reach the uterus and may implant itself in the oviduct wall (ectopic or tubal pregnancy).Because of its small diameter and inability to expand, the tube cannot contain the growing embryo and will rupture, causing extensive hemorrhage that can be fatal if not treated immediately.